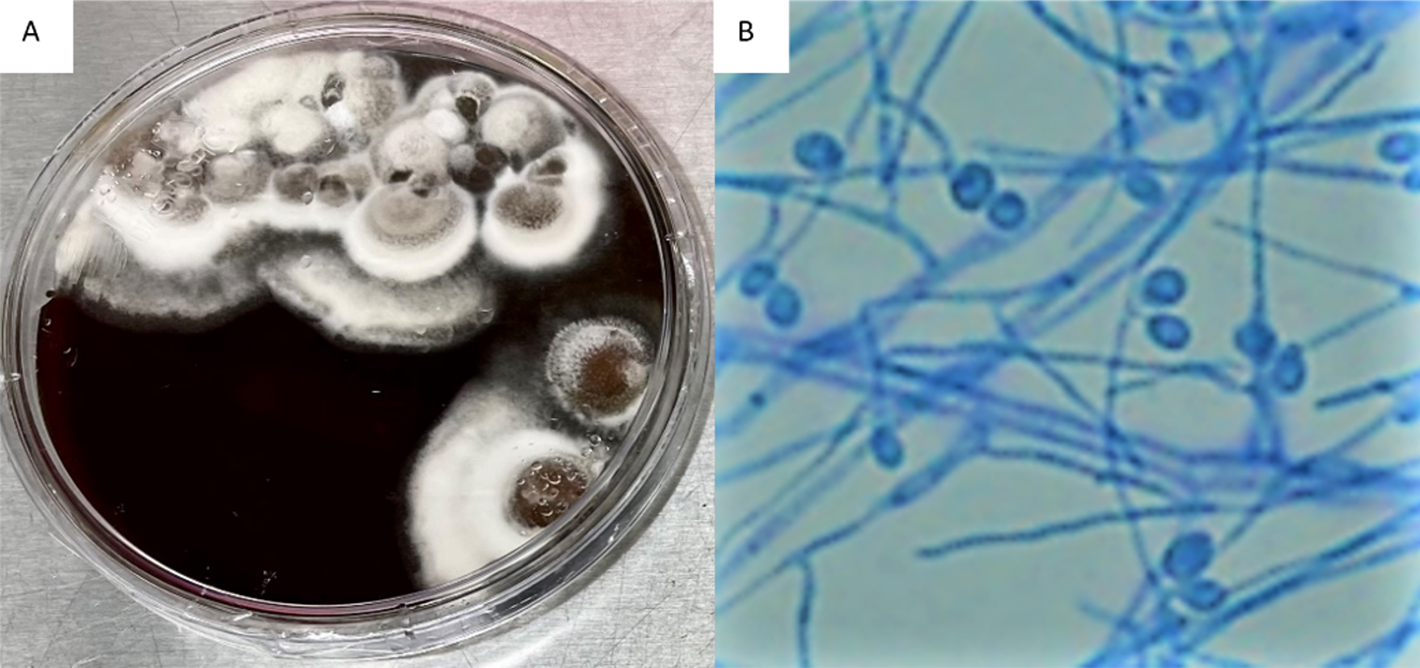

August 2023 Case
Clinical History
Female in her 60’s with a history of chronic hepatitis B complicated by hepatocellular carcinoma, status post orthotopic liver transplant 5 months ago, presented with blurry vision and painful bilateral foot nodules, concerning for endocarditis with septic emboli.
Upon admission, brain CT-scan showed small left parietal lobe infarction with a small area of hemorrhagic conversion. Brain MRI revealed left-sided posterior frontal, parietal, and posterior temporal ring-enhancing lesions with surrounding edema, confirming septic emboli. Ophthalmic evaluation raised suspicion for infection in the left eye concerning for retinal emboli. Abdominopelvic CT-scan showed retroperitoneal abscess, which was drained. Cardiologic evaluation included a TTE and TEE, showed vegetation in the papillary muscle of the mitral valve concerning for infectious endocarditis.
Workup of retroperitoneal abscess drainage, brain lesion, and right foot nodule biopsy revealed suppurative mixed non-necrotizing granulomatous inflammation with narrow septate fungal hyphae with a random branching pattern with a few areas displaying 45° angle branching pattern. (Figure 1).

Figure 1. Skin nodule and soft tissue biopsy. Branching fungal hyphae, PAS staining (A), and GMS staining (B)
Culture
The patient was started on Voriconazole, her condition worsened due to an intraparenchymal brain hemorrhage due to rupture of a cerebral aneurysm. Her course was further complicated by acute hypoxic respiratory failure, requiring emergent intubation, and subsequent development of ARDS. She had multiple episodes of mixed cardiogenic/septic shock, worsening mitral regurgitation resulting in hypotension, and severe pulmonary edema. Due to her poor condition, the decision was made to transition to comfort care.
Figure 2. Brain Heart Infusion (BHI) Agar plate growing Scedosporium apiospermum (A), Scedosporium apiospermum septate hyphae & conidia (B)
Clinical Course
Fungal cultures of the retroperitoneal abscess and leg nodules were positive for a filamentous fungus on day 4. The white to gray colonies grew at 30° C on Brain Heart Infusion (BHI) Agar (Figure 2A) and Inhibitory Mold Agar (IMA). The mold was examined microscopically using a Lacto-phenol cotton blue adhesive tape preparation and showed septate hyphae (2-4 um in width) with unicellular conidia (Figure 2B). The organism was morphologically identified as Scedosporium species and confirmed as Scedosporium apiospermum using MALDI-TOF (matrix-assisted laser desorption/ionization) mass spectrometry.
A Karius liquid biopsy test on patient's plasma was also performed and results agreed with the Scedosporium culture result. of ARDS. She had multiple episodes of mixed cardiogenic/septic shock, worsening mitral regurgitation resulting in hypotension, and severe pulmonary edema. Due to her poor condition, the decision was made to transition to comfort care.
Discussion
Disseminated Scedosporium apiospermum infection involving the brain is a severe and potentially life-threatening condition, particularly in immunocompromised individuals. S. apiospermum is a filamentous fungus commonly found in the environment (soils, polluted water, composts, and manure). It can cause opportunistic infections in susceptible hosts, such as organ transplant recipients, patients with hematologic malignancies, and those with compromised immune systems. The taxonomy of this genus has been subject to change due to updated sequence data with the primary human pathogens now recognized to be S. apiospermum, S. boydii, and S. aurantiacum. Preventing fungal infections in immunocompromised patients, such as liver transplant recipients, includes meticulous infection control measures, appropriate prophylactic antifungal therapy, and minimizing exposure to environmental sources of the fungus.
Patients with disseminated Scedosporium infection involving the brain may present with a range of symptoms, depending on the extent and location of the infection. Common clinical manifestations may include fever, neurological symptoms (headache, confusion, altered mental status, seizures, and focal neurological deficits may result from the fungal invasion of brain tissue, leading to abscess formation or meningoencephalitis), respiratory symptoms (cough, shortness of breath, and chest pain, as the fungus can involve the lungs), skin lesions (cutaneous involvement or septic emboli may lead to the appearance of skin lesions or nodules).
Diagnosing disseminated Scedosporium infection requires a combination of clinical evaluation, imaging studies, pathology, and culturing the fungus from relevant specimen sites, including CSF, brain, respiratory and skin. Molecular techniques, such as polymerase chain reaction (PCR) or sequencing may assist with the identification of the causative fungus if cultures are unsuccessful.
Managing disseminated Scedosporium apiospermum infection is challenging and requires a comprehensive approach; Intravenous antifungal agents are the mainstay of treatment. Voriconazole is often considered the drug of choice for Scedosporium infections, but other agents, such as posaconazole and isavuconazole, may also be used. Combination therapy or sequential treatment with different antifungal agents may be considered in severe cases or in the presence of drug resistance. Surgical Intervention in cases of large or accessible brain abscesses, surgical drainage and debridement can be beneficial to reduce the fungal burden and enhance the effectiveness of antifungal therapy. If the patient has received a solid organ transplant, the immunosuppressive regimen should be reevaluated to minimize the risk of further immunosuppression-related complications. Symptomatic and supportive care, including management of neurological symptoms, fever control, and nutritional support, is essential for optimizing patient outcomes.
The prognosis for disseminated Scedosporium apiospermum infection involving the brain is generally guarded, especially in immunocompromised patients. Early diagnosis, prompt initiation of appropriate antifungal therapy, and timely surgical intervention when feasible can improve outcomes. However, the overall mortality rate remains significant, and neurological sequelae may persist even with successful treatment.
In conclusion, disseminated Scedosporium apiospermum infection involving the brain is a severe and complex medical condition requiring prompt diagnosis and aggressive multidisciplinary management. Close collaboration among infectious disease specialists, neurologists, neurosurgeons, and other relevant healthcare providers is crucial for improving patient outcomes.
References
- Siegel RL, Miller KD, Wagle NS, Jemal A. Cancer statistics, 2023. CA Cancer J Clin 2023;73(1):17-48. DOI: 10.3322/caac.21763.
- Pham D, Bhandari S, Pinkston C, Oechsli M, Kloecker G. Lung Cancer Screening Registry Reveals Low-dose CT Screening Remains Heavily Underutilized. Clin Lung Cancer 2020;21(3):e206-e211. DOI: 10.1016/j.cllc.2019.09.002.
- Gould MK, Tang T, Liu IL, et al. Recent Trends in the Identification of Incidental Pulmonary Nodules. Am J Respir Crit Care Med 2015;192(10):1208-14. DOI: 10.1164/rccm.201505-0990OC.
- Agrawal A, Hogarth DK, Murgu S. Robotic bronchoscopy for pulmonary lesions: a review of existing technologies and clinical data. J Thorac Dis 2020;12(6):3279-3286. DOI: 10.21037/jtd.2020.03.35.